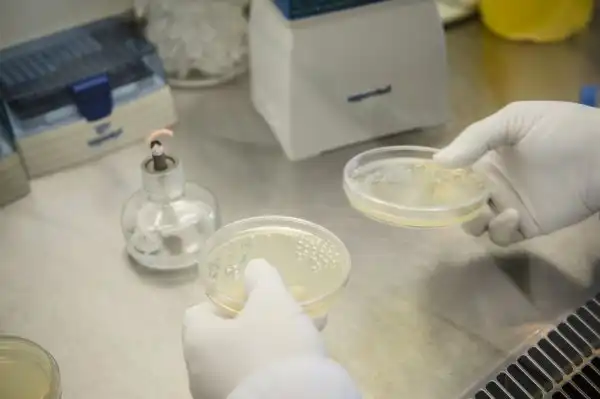

Вот уже почти 15 лет российская компания BIOCAD разрабатывает уникальные технологии, борющиеся с раком.
Компания BIOCAD — детище успешного российского банкира Дмитрия Морозова, в 2001 году задавшегося амбициозной целью победить главную чуму 21-го века и построить успешный бизнес, инвестируя средства в российскую науку. На сегодняшний день компания имеет в штате более 1000 человек и представляет на рынок РФ более 30 продуктов, восемь из которых — готовые биотехнологические препараты, лидирующие в своем сегменте. Мало того, в прошлом году BIOCAD стал самой инновационной компанией России и получил первую национальную премию «Индустрия» за реализацию уникального проекта MABNEXT по разработке инновационных препаратов для лечения онкологических и аутоиммунных заболеваний.
Говоря простым, ненаучным языком, существуют два принципиальных пути борьбы со сложными заболеваниями. Первый — поиск белка-антитела, способного помочь естественным иммунным механизмам организма, ежедневно отбивающимся от тысяч угроз, справиться с заболеванием. Второй — поиск химического соединения, способного прицельно уничтожить раковые клетки с минимальным ущербом для их здоровых соседей.
BIOCAD работает в обоих направлениях. Именно поэтому научных кластеров у компании два — собственно, биологический и химический. Причем каждая лаборатория трудится как над производством биоаналогов (то есть импортозамещающих препаратов, схожих по параметрам эффективности и безопасности с уже существующими западными лекарствами), так и над собственными продуктами с оригинальной формулой.
Биологическая лаборатория — тот самый проект MABNEXT — расположена непосредственно в головном офисе компании. Выпущенный в прошлом году в серийное производство препарат, борющийся с лимфомой и лимфолейкозом и ставший на данный момент визитной карточкой компании, — их рук дело. Другие проекты, которыми сегодня занимаются сотрудники биолаборатории, направлены на борьбу с раком легких, молочной и поджелудочной желез, печени, головы и шеи. Кроме того, лаборатория выпускает препараты для лечения аутоимунных заболеваний, побеждающие такие болезни, как, например, рассеянный склероз, псориаз или ревматоидный артрит.
Лаборатория состоит из целого ряда тесно связанных друг с другом департаментов — молекулярной генетики и клеточных технологий, биохимии и биоинформатики, департаментов разработки лекарственных средств, доклинических и клинических испытаний. Логика создания препарата примерно такова. После того как выбрано общее направление разработки, создается теоретический образ искомой «целительной» молекулы. Затем наступает так называемый этап «генерации библиотеки», когда из всего созданного (или полученного из природы) разнообразия антител отбираются те, что отвечают конкретным поставленным целям. Изначально библиотека может содержать миллиарды различных единиц (все они уже содержатся в нашей с вами крови), и одна из ключевых фаз разработки препарата заключается как раз в том, чтобы отобрать именно те несколько из них, что наилучшим образом отвечают всему перечню необходимых параметров: эффективность, стабильность, безопасность и еще полсотни других. Как легко догадаться, лаборатория укомплектована сложнейшим оборудованием, с помощью которого и осуществляется вся процедура отбора. Далее наступает этап работы с уже отобранным белком — наработка, выделение, культивация и «фармацевтическая разработка». И уже после этого — самая продолжительная, финальная стадия — доклинические и клинические исследования безопасности и эффективности полученного препарата. Суммарно процесс производства одного такого лекарства длится около пяти лет.
Химический департамент, занимающийся проектами CHEMNEXT и дженериков, расположен в трех километрах от главного офиса и разрабатывает активные фармацевтические субстанции. Это подразделение компании молодое, в данный момент представляющее собой два отдела — синтетических разработок (где, собственно, и создается лечащий «концентрат» будущего лекарства) и масштабирования (отвечающий за наработку субстанции и улучшение процессов благодаря новым технологиям). Старт непосредственного производства продуктов химической лаборатории планируется на 2016 год. Сегодня здесь разрабатывают препараты от хронического гепатита С, а также от нескольких видов рака, таких как меланома, лимфома и лейкоз.
Кстати, о самих заболеваниях: помимо чисто фармацевтической деятельности, BIOCAD уже несколько лет ведет ряд социально-образовательных программ, помогающих пациентам с тем или иным диагнозом сориентироваться и получить ответы на все возможные вопросы. Так, под эгидой головного бренда работает платформа «Миродин» (информационный портал о гепатите и ВИЧ), а также ведется ряд благотворительных программ с исследовательскими и диагностическими центрами. В 2013 году BIOCAD создал уникальный в своем роде интернет-ресурс «Курс на выздоровление», при помощи которого пациенты имеют возможность оставить заявку на препараты компании в законно работающих, лицензированных аптеках на условиях от производителя.
Легко догадаться, что BIOCAD стал, без преувеличений, настоящей работой мечты, своего рода «Гуглом» для молодых российских химиков, биологов и фармацевтов, стремящихся перевернуть ход истории. Эту самую «сбычу мечт» компания воплощает, предоставляя всё новые рабочие места и собирая лучшие молодые кадры под своей крышей. BIOCAD на регулярной основе сотрудничает с 15 целевыми российскими вузами, в том числе Санкт-Петербургской химико-фармацевтической академией, где ведет отдельную кафедру и ежегодно забирает в штат 10-15 лучших студентов, Академическим университетом Ж. Алфёрова, Физико-техническим институтом им. А.Ф. Иоффе РАН и другими. Показательно, что средний возраст ученых-исследователей, коих сегодня в компании более 300 человек, составляет 28 лет. Все действительно очень молодые и красивые.
Самое же главное, что сразу замечаешь при личном контакте и что, увы, трудно передать текстом, — тот самый блеск в глазах. Никакого приукрашивания, это действительно первое, на что обращаешь внимание, попадая на территорию компании. Ребята не только ежедневно занимаются любимым делом, получая массу возможностей для расширения знаний и обмена опытом. Они по-настоящему вдохновлены и заряжены той высокой миссией, что была заложена в фундамент компании изначально, — спасти человечество от рака. И глядя на то, что им удалось сделать за это, пока еще совсем непродолжительное время, в успех этой миссии верится очень легко.